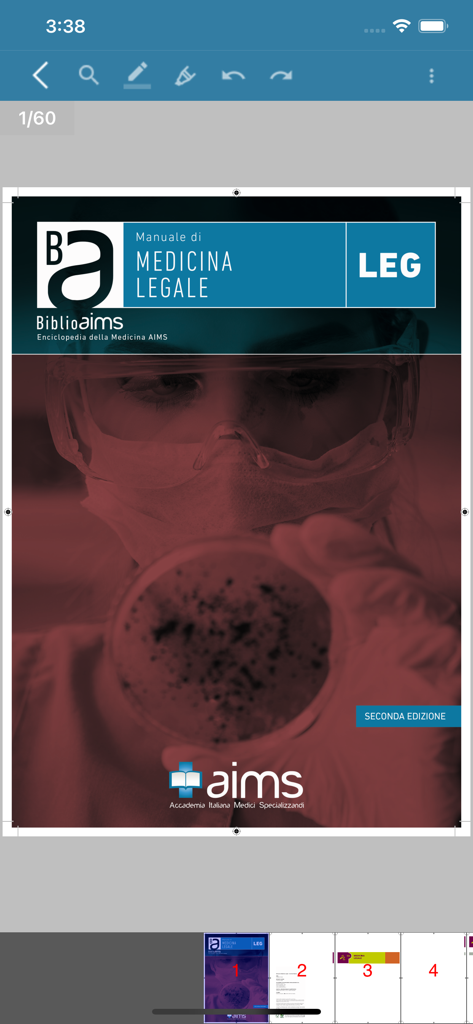
Manuali AIMS - Digital cover of a Forensic Medicine study manual within the Manuali AIMS mobile application.

This page is not an official page of the app or its developer, but an independent editorial publication created for informational and commentary purposes. Unless expressly stated otherwise, neither the app nor its developer is affiliated with, endorsed by, sponsored by, authorized by, or otherwise officially connected with MWM, Apple, Google Play, the app publisher, or the app's developer, and nothing on this page implies that the app was developed using MWM's services. Any trademarks, logos, screenshots, and other content remain the property of their respective owners.
Manuali AIMS
Master your medical residency preparation with schematic, up-to-date digital manuals. Access the innovative AIMS method offline, highlight key concepts, and study anywhere without the weight of physical textbooks.
Downloads
15K+User Rating
Total Ratings
0Publisher
Category
MedicalLocales
2Latest Version
1.5.1Size
59.6 MBFirst Released
Oct 8, 2020Optimized Study for Future Specialists
Carry the power of AIMS manuals in your pocket. Our digital platform is engineered for high-intensity medical preparation, providing the schematic clarity you need to succeed in the SSM and MMG exams.
High-Yield Schematic Content
Master complex medical topics through concise, concrete summaries updated with the latest clinical guidelines, designed for maximum exam-day efficiency.
Complete Offline Portability
Study without limits. Download your manuals once and access them anywhere—perfect for hospital rounds, commutes, or areas with no connectivity.
More Like This
Top-ranked apps in the same category

国家医保服务平台
National Healthcare Security Administration

MyChart
Epic Systems Corporation

Doctolib - Your health partner
Doctolib

Pregnancy + | Tracker App
Philips Digital UK Limited

CVS Health
CVS Pharmacy

江苏医保云
Jiangsu Healthcare Security Bureau

UnitedHealthcare
UNITED HEALTHCARE SERVICES, INC.

京东健康
BEIJING JINGDONG 360 DU E-COMMERCE LTD.

Meu SUS Digital
Servicos e Informacoes do Brasil
This page is not an official page of the app or its developer, but an independent editorial publication created for informational and commentary purposes. Unless expressly stated otherwise, neither the app nor its developer is affiliated with, endorsed by, sponsored by, authorized by, or otherwise officially connected with MWM, Apple, Google Play, the app publisher, or the app's developer, and nothing on this page implies that the app was developed using MWM's services. Any trademarks, logos, screenshots, and other content remain the property of their respective owners.